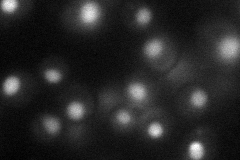
YDL030W
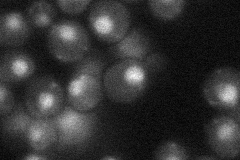
YDL030W
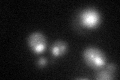
YDL030W
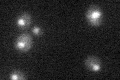
YDL030W

View description
Subunit of the SF3a splicing factor complex, required for spliceosome assembly; acts after the formation of the U1 snRNP-pre-mRNA complex
Localization:
Intensity:
Fold change:
Significance:
-
C’ GFP library in SD

nucleus25.13 -
N' NOP1pr-GFP in SD
nucleus45.2194 -
N' TEF2pr-mCherry in SD

nucleus26.398 -
N' NATIVEpr-GFP in SD
nucleus27.7924 -
N' TEF2pr-VC and Cyto-VN in SD

below threshold26.1131 -
C’ GFP library in SD+DTT
nucleus25.391.01No -
C’ GFP library in SD+H2O2

nucleus281.11No -
C’ GFP library in Starvation Media
nucleus21.350.84No -
C’ GFP library on the background of Pup2-DaMP

nucleus -
C’ GFP library on the background of CCT mutant

nucleus26.72991.0635No
